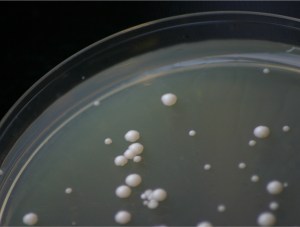
DeependedCoopUnderstanding

Research Highlights
In collaboration with colleagues from around the world and in particular with Beardmore lab we have

Generated new theory: We have discovered a new general mechanism of stable diversity maintenance in simple homogeneous environments (Beardmore et al, Nature 2011) and developed a new general theory finally explaining why most parasites have narrow host ranges (Sieber and Gudelj, Ecology Letters 2014). We have also proposed tipping (in the context of tipping points) as a new mechanism for understanding the dynamics of drug-resistance in mixed species communities following exposure to antibiotics (Beardmore et al, Nature Ecology & Evolution 2018).

Constructed and carried out tests of seminal but untested theories: We provided the first empirical test of the longstanding and open conjecture that trade-off geometry determines the response to selection, the dynamics of gene frequencies and ultimately biodiversity (Maharjan et al, Ecology Letters 2013) and that the geometry can be inferred directly from the biophysical mechanisms that cause trade-offs (Meyer et al, Nature Communications 2014). More, recently we demonstrated that the classical growth rate(r)-carrying capacity (K) selection theory does not hold in carbon-poor environments which can lead to microorganisms growing faster and to higher densities in the presence of antibiotics (Reding-Roman et al, Nature Ecology & Evolution 2017).

Begun to bridge the gap between laboratory and natural studies: We have shown that a combination of laboratory systems and appropriately configured mathematical models is an effective means to isolate results particular to the in vitro system, characterise systems likely to behave differently and to understand the biology underpinning those alternatives (Forde et al, Nature 2008).
Deepened our understanding of microbial cooperation: We have shown that coexistence between cooperative and selfish resource users is driven by a trade-off between the rate and efficiency of the conversion of resources into offspring (MacLean and Gudelj, Nature 2006) and that the common assumption that groups are best off if all individuals cooperate does not always hold true (MacLean et al, Plos Biology 2010). The latter result is also a feature of many host-pathogen systems which can have devastating consequences for a promising anti-virulence disease management strategy (Lindsay et al, eLife 2016).